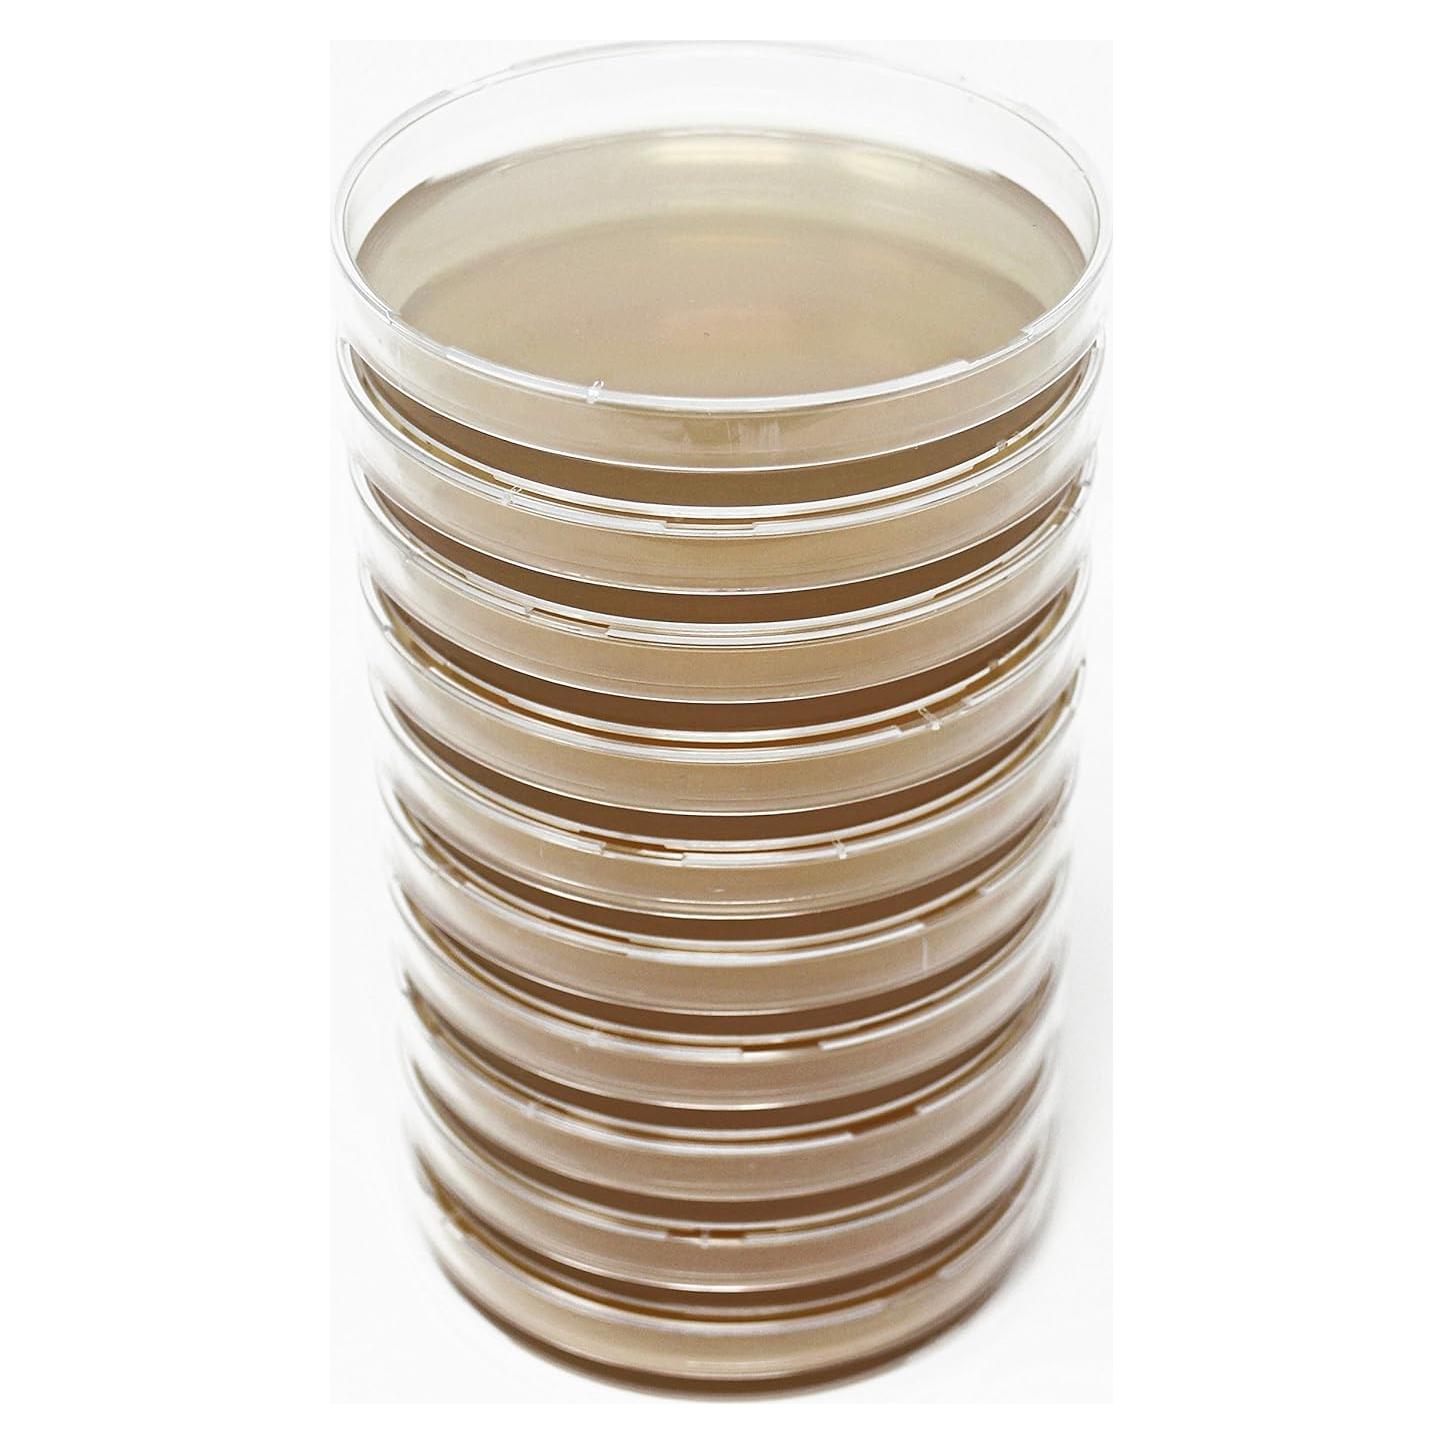
Placas de Agar de Extracto de Malta MEA EZ BioResearch - 10 Unidades

Best Naturals
Enzima Pectica Líquida Grado Alimenticio 14g Home Brew Ohio






$31.982
+ impuestos: $6.716
- Compra protegida
- Envío a todo el país
- Garantía de entrega
Características destacadas
- Elimina la neblina de pectina del vino
- Grado alimenticio
- Usado en la elaboración de vino
Opiniones de compradores
325 opiniones
Merridee Gibson
Worked very well, using same 15-20 drops in cool water (half a gallon approx) and about ten mandarins I let them sit over night stirred them up and massaged a bit the next day and they made beautiful little four ounce jars of mandarins for school lunches water bath canned for 10 minutes with a simple syrup of 1/4cup sugar to two cups of hot water.
Noah Arts
Keep this in the fridge or frozen!Good product and works well. I used it in my meads and wines to help fruit heavy batches clear up and it works wonders.Some negative things: The amount of enzyme reccomended to be used was not given (so many drops per liter). Or the concentration of their solution so one could work out how much they need themselfs.This information is available on the page but it should be included with the product
AmazonGoogler
I'm leaving a review for a very specific use case that vexxed me for years: How to stop my fresh tomatillo salsa verde from turning to jelly in the refrigerator. I looked everywhere and read everything available to me to try and find a solution and could never get clear guidance, so if that is you also, then here you go: buy this.I roasted 12-14 tomatillos, onion, garlic, and about 6oz of hatch chilies and then pureed them in a vitamix. It yielded enough to fill a Ball quart jar. I split the ...
Kevin brouillette
Works well at dissolving the pith off of oranges for canning
J. W. Hennessy
The sap from Black Walnut trees has a good deal of pectin in it. When I have boiled sap without adding pectic enzyme the syrup is very hard to filter as it develops a 'jelly' like substance.To combat this I add ten drops of pectic enzyme per gallon of sap, stir it in and wait 24 hours for it to fully activate. Since I started using this product I have never had a filtering problem. I typically get about 440 drops per bottle, ergo, enough to treat 44 gallons of sap. Gotta love it!
Descripción
Especificaciones técnicas
- Fabricante
- Home Brew Ohio
- Dimensiones del producto
- 1 x 1 x 6.35 cm; 14.17 gramos
- Número de modelo del artículo
- 07-51HT-KHOG
- Está descontinuado por el fabricante
- No
Preguntas y respuestas
Tu pregunta fue enviada. Te responderemos pronto.
¿Dónde te enviamos la respuesta?
Tus preguntas
· Recibirás la respuesta a
Productos relacionados
Kneadace
Cultura de Inicio de Masa Madre KneadAce 680g - Levadura Natural
EZ BioResearch